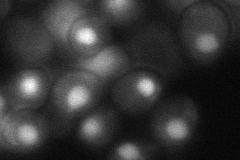

View description
SUMO-conjugating enzyme involved in the Smt3p conjugation pathway; nuclear protein required for S- and M-phase cyclin degradation and mitotic control; involved in proteolysis mediated by the anaphase-promoting complex cyclosome (APCC)
Localization:
Intensity:
Fold change:
Significance:
-
C’ GFP library in SD

below threshold17.86 -
N' NOP1pr-GFP in SD

nucleus83.1386 -
N' TEF2pr-mCherry in SD

nucleus150.817 -
N' NATIVEpr-GFP in SD

nucleus37.2284 -
N' TEF2pr-VC and Cyto-VN in SD
nucleus66.5545 -
C’ GFP library in SD+DTT

cytosol12.670.7No -
C’ GFP library in SD+H2O2

cytosol15.520.86No -
C’ GFP library in Starvation Media

cytosol16.370.91No -
C’ GFP library on the background of Pup2-DaMP

below threshold -
C’ GFP library on the background of CCT mutant

below threshold17.97261.00587No
